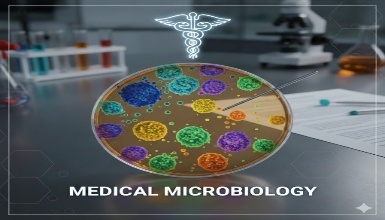
Medical Microbiology

Science Certification Courses
Courses to get you started
Most Popular

Featured

Best Seller

Explore All Science Certification Courses
Expand your knowledge and expertise with our comprehensive range of Science courses. Designed to keep you informed about the latest industry trends and advancements... These courses offer valuable insights and practical skills to enhance your professional journey.
Popular Searches